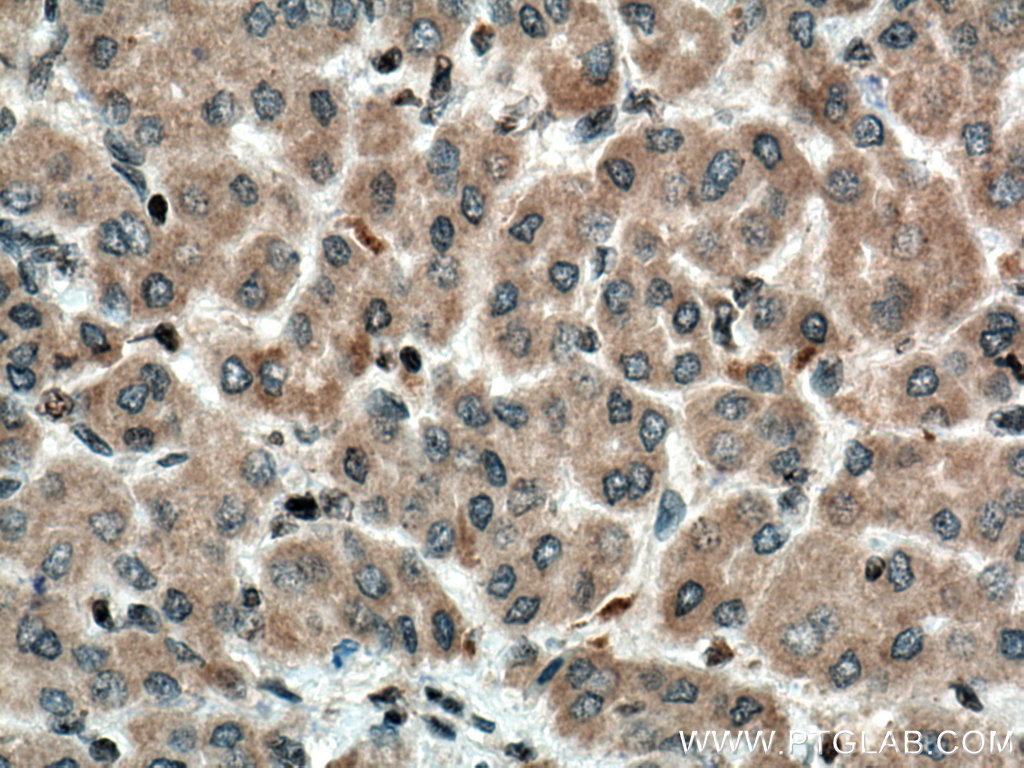

验证数据展示
经过测试的应用
| Positive WB detected in | MCF-7 cells, A549 cells, mouse brain tissue, rabbit brain tissue, rat brain tissue, U-251 cells |
| Positive IHC detected in | human breast cancer tissue, human liver cancer tissue Note: suggested antigen retrieval with TE buffer pH 9.0; (*) Alternatively, antigen retrieval may be performed with citrate buffer pH 6.0 |
推荐稀释比
| 应用 | 推荐稀释比 |
|---|---|
| Western Blot (WB) | WB : 1:1000-1:6000 |
| Immunohistochemistry (IHC) | IHC : 1:150-1:600 |
| It is recommended that this reagent should be titrated in each testing system to obtain optimal results. | |
| Sample-dependent, Check data in validation data gallery. | |
产品信息
66511-1-Ig targets MDM2/HDM2 in WB, IHC, IF, IP, CoIP, ELISA applications and shows reactivity with human, mouse, rat, rabbit samples.
| 经测试应用 | WB, IHC, ELISA Application Description |
| 文献引用应用 | WB, IHC, IF, IP, CoIP |
| 经测试反应性 | human, mouse, rat, rabbit |
| 文献引用反应性 | human, mouse, rat |
| 免疫原 |
Peptide 种属同源性预测 |
| 宿主/亚型 | Mouse / IgG2b |
| 抗体类别 | Monoclonal |
| 产品类型 | Antibody |
| 全称 | Mdm2 p53 binding protein homolog (mouse) |
| 别名 | MDM2, 2A6C9, E3 ubiquitin-protein ligase Mdm2, EC:2.3.2.27, hdm2 |
| 计算分子量 | 55 kDa |
| 观测分子量 | 40-55 kDa |
| GenBank蛋白编号 | NM_002392 |
| 基因名称 | MDM2 |
| Gene ID (NCBI) | 4193 |
| RRID | AB_2881874 |
| 偶联类型 | Unconjugated |
| 形式 | Liquid |
| 纯化方式 | Protein A purification |
| UNIPROT ID | Q00987 |
| 储存缓冲液 | PBS with 0.02% sodium azide and 50% glycerol, pH 7.3. |
| 储存条件 | Store at -20°C. Stable for one year after shipment. Aliquoting is unnecessary for -20oC storage. |
背景介绍
What is the cellular localization of MDM2?
MDM2 is predominantly localized in the nucleoplasm.
What is the tissue specificity of MDM2?
MDM2 is non-specific, expressing ubiquitously in the brain, heart, kidney, skin, and other tissues. Certain
isoforms only express in cancerous cells and not normal tissue.
With what other molecules does MDM2 interact?
Most notably, the oncogene protein MDM2 regulates transcription factor p53 by binding its transcriptional
activation domain and by E3-ubiquitin ligase activity. Ribosome proteins rpL5, rpL11, and rpL23 also bind to
MDM2, inhibiting E3 ubiquitin ligase activity and promoting the p53 pathway.
What competes with MDM2 activity?
Nutilin-3 was designed to compete with MDM2 in binding with p53, inducing activation of the p53 pathway.
What is the role of ubiquitination in MDM2 activity?
While p53 is also affected by other post-translational modifications, its stability is determined by ubiquitination
mediation of MDM2, suppressing p53 transcriptional regulation and leading to the proteosomal degradation of
p53.
How is MDM2 associated with cancer?
MDM2 inhibits the activity of the tumor-suppressive protein p53, which serves as an important factor in
promoting DNA repair or activating apoptotic pathways. Loss of p53 is associated with tumor development
and growth.
What is the human ortholog of MDM2?
Human double-minute type 2 (HDM2)
In what cellular circumstances does the p53-MDM2 complex dissociate?
Cellular stress or DNA damage result in the phosphorylation and activation of p53. Phosphorylation also
prevents p53-MDM2 interaction.
Where is the gene located?
Hdm2 is located on human 12q15.
Mdm2 is located on murine 10 D2.
PMIDs: 24309898, 29584707, 9840926, 28714398
实验方案
| Product Specific Protocols | |
|---|---|
| IHC protocol for MDM2/HDM2 antibody 66511-1-Ig | Download protocol |
| WB protocol for MDM2/HDM2 antibody 66511-1-Ig | Download protocol |
| Standard Protocols | |
|---|---|
| Click here to view our Standard Protocols |
发表文章
| Species | Application | Title |
|---|---|---|
Redox Biol A new FGF1 variant protects against adriamycin-induced cardiotoxicity via modulating p53 activity. | ||
Cell Death Discov LASS2 enhances p53 protein stability and nuclear import to suppress liver cancer progression through interaction with MDM2/MDMX | ||
Cell Death Discov hMOF induces cisplatin resistance of ovarian cancer by regulating the stability and expression of MDM2 | ||
Oncogenesis MeCP2 facilitates breast cancer growth via promoting ubiquitination-mediated P53 degradation by inhibiting RPL5/RPL11 transcription. | ||
Int J Biol Sci Flap endonuclease 1 Facilitated Hepatocellular Carcinoma Progression by Enhancing USP7/MDM2-mediated P53 Inactivation. | ||
J Cell Mol Med LncRNA MIAT enhances cerebral ischaemia/reperfusion injury in rat model via interacting with EGLN2 and reduces its ubiquitin-mediated degradation. |